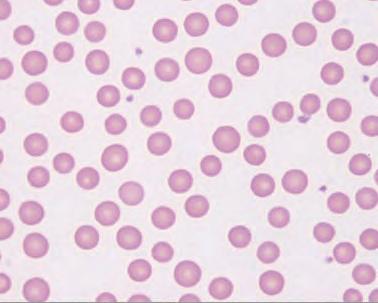

8 minute read
Tackling Anaplaz
by Teres Lambert, for the Red Angus Magazine
Buzzards circling in diff erent areas of a large pasture aren’t a sight any cattle producer wants to see. But that is what commercial cowman Rick Warner, Throckmorton, Texas, faced.
“I have a fall-calving set of cows that I had checked at weaning July 1 and left on their own until checking them at calving. We run cows in big country, and I was busy farming,” Warner said. “When I nally got around to checking the herd at calving, I was a few head of cattle short—the reason for the buzzards a-circling.”
Warner’s veterinarian pulled blood on suspects. Test results con rmed anaplasmosis.
While beef producers in the South and Southeast typically have anaplasmosis on their radar, since the disease is endemic to that area, this infectious disease has been found within all continental states. And it is taking a chunk from the bottom lines of infected herds.
Researchers estimate that the introduction of anaplasmosis into a previously naïve herd can result in a 3.6% reduction in calf crop, a 30% increase in cull rate and a 30% mortality rate in clinically infected adult cattle. This amounts to approximately $400 per animal – that’s approximately a $1 billion loss to the industry per year.
“In one particular pasture I lost 11 cows and 15 pregnancies,” Warner stated. “I had preg-checked and knew those females were pregnant, but they came up dry due to anaplaz. That was costly.”
The pathogen that causes anaplasmosis, Anaplasma marginale, is introduced into an animal’s bloodstream by blood transfer. In the past eight or so years, researchers have found more than 100 strains of the pathogen across the country – and individual animals have been known to carry more than one A. marginale strain at a time.
While anaplasmosis was a key concern among cattle producers in the 1960s and 1970s, it entered the spotlight again within the past 10 years.
Dr. Greg Hanzilcek, clinical associate professor, Kansas State University Diagnostic Laboratory, Manhattan, Kansas, said, “More and more producers are talking about anaplasmosis now because they are understanding what it is and are looking for it. And there is more accurate testing for the disease.”
Hanzilacek notes that cattle movement is believed to be the reason for anaplasmosis reappearing and spreading. Texas and Oklahoma went through a major drought in 20102012, and cattle in these anaplasmosis-endemic states were moved to other states.
“Once anaplasmosis-positive animals are in a herd, the disease can spread quite quickly,” Hanzilacek said.







Those Darn Ticks, Flies
The transmission of the pathogen from an anaplasmosis-positive animal being injected into the bloodstream of an anaplasmosis-negative animal occurs in two ways: biologically and mechanically. Key culprits of biological transmission are ticks, horse ies and deer ies.
“While ies are known to transmit anaplasmosis, I would say that ticks are the key source of anaplasmosis across herds,” said Hanzilacek. “When a tick takes a blood meal, the organism multiplies tremendously in the tick, amplifying the number of bacteria. After a male tick feeds on an animal, it will drop off , then nd another animal to feed on.
“If the rst animal is anaplasmosis-positive, then the tick will transmit the bacteria through its saliva when feeding on a subsequent uninfected animal.”
Within-herd transmission is frequently at the hands of humans. Contaminated blood can be exchanged via injection and implant needles, tattoo pliers, dehorning instruments and castration tools.
“It doesn’t take much blood on a needle – or other appliance – from a positive animal to be injected into a negative animal,” Hanzilacek added.
Transmission can also occur between an infected dam and her unborn calf. Up to 16% of calves born to positive anaplasmosis cows will be positive anaplasmosis carriers at birth.
On the Way to Becoming Anemic
Once in the blood, the pathogen parasitizes in an animal’s red blood cells. The disease progresses rapidly, with the percentage of cells infected doubling each day once the 1% threshold is reached. • Test purchased animals. • Quarantine purchased animals until test results con rm negative for anaplasmosis. • Change needles between animals.
• Disinfect tattoo pliers, castrating instruments and dehorning instruments between animals.
• Control ticks and ies and understand that common external parasite treatments for cattle are not particularly eff ective against these species.
Kansas State University veterinarian Gregg Hanzlicek said that a research project found six out of 10 animals became infected just from moving an injection/vaccination needle from an anaplasmosis-positive animal to an anaplasmosis-negative animal.
Management practices that can help lessen the spread of anaplasmosis:

In an eff ort to clear the infection, an animal’s immune system removes and destroys the infected RBCs. Once 50% of their RBCs have been destroyed, animals exhibit signs of anemia: dark yellow urine, lagging behind the herd, refusal to eat or drink, diffi culty breathing (particularly when moved) and pale skin around the eyes, muzzle, lips and teats. Pregnant females that become infected may abort.
Highly infected animals tend to stay apart from the herd with neck extended with labored open-mouth breathing, may exhibit aggressive behavior and disorientation and may be found dead in the pasture – such as what Warner experienced.
Research shows that 30% to 50% of infected cattle more than three years of age will die without early treatment.
“It is important to remember things other than anaplasmosis may kill adult animals or cause these clinical signs,” said Hanzilacek. “If a producer sees any of the signs mentioned, contact a local veterinarian to assist with the diagnosis.” Researchers have found that, while cattle one to three years of age may exhibit severe clinical signs, they typically recover from the disease.
The negative news is that recovered animals remain lifelong carriers.
Although lifelong carriers will not experience anaplasmosis in subsequent years, they are a source of infection for other animals. If a carrier animal is re-infected, it will not, however, show clinical signs the second time.
Late summer and fall are good times to check for anaplasmosis, as cases typically increase as insect vectors increase. Non-infected blood
Red blood cells infected with anaplasmosis bacteria
Therapy Challenges
With anaplasmosis, therapy has three strikes against it: 1) the disease can often be too late to treat by the time it is diagnosed; 2) therapy hinges on the strain of A. marginale causing the disease and 3) therapy for anaplasmosis is limited and treatments do little or nothing to aff ect the outcome of the disease when given after clinical signs are observed.

Warner, who runs 1,000 commercial mother cows, is among those trying to control the disease by feeding mineral with chlortetracyline. Commonly called CTC, chlortetracycline is the only antimicrobial approval for control of anaplasmosis.
“I worked with my veterinarian to develop the program, and our problem dwindled after being on that program for a year,” said Warner. “I know now to stay ahead of the disease because it can be so costly if I don’t.”
Currently no commercial vaccine is available to control anaplasmosis. Producers do have access to an experimental vaccine, but the vaccine has no published results regarding eff ectiveness and does require permission from your state veterinarian to use. Kansas State University’s College of Veterinary Medicine’s single-dose implant vaccine which would be administered in the back of the ear and deliver lifelong protection off ers hope for producers but remains under development.


It’s time to round-up the data for the





The onset of the IGS-BOLT evaluation, paired with the submission of phenotypic records, has led to a new era in genetic evaluation for the cattle industry. In an effort to collect necessary female genotype and phenotype information to improve genetic predictions, the Red Angus Association of America Board of Directors has approved the Red Cow Rally.
The Rally research collaboration between RAAA and Neogen is designed to increase phenotypic data collection and submission for mature weights, body condition scores and genotypes on Red Angus females. A limited number of research genotypes (GGP-LD) and rebate funds will be available for the project, so discounts and rebates will be issued on a fi rst-come, fi rst-served basis.
A a r
Visit RedAngus.org/red-cow-rally
TO ENROLL: T Kai Miranda, K
DNA Customer D Service Specialist S 940-387-3502, Ext. 24 9 kai@redangus.org k
